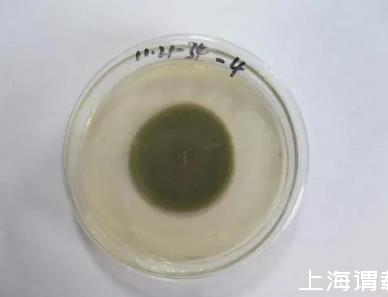

發酵培養基有哪些成分組成,和種子培養基的不同
發酵培養基優化,是從事微生物發酵研究經常面臨的問題,也是至關重要的一個環節,合理的方法和實驗設計是成敗的關鍵。
發酵培養基有哪些成分組成
發酵條件對產物的形成有著非常重要的影響,其中培養基pH、培養溫度和通氣狀況是三類最主要的發酵條件。培養基pH一般指滅菌前的pH,可通過酸堿調節來控制,由于發酵過程中pH會不斷改變,所以最好用緩沖溶液來調節;通氣狀況可用培養基裝量和搖床轉速來衡量,另外,瓶口布的厚薄也會影響到氧氣的傳遞,為了防止雜菌污染,瓶口布以8層紗布為好。
發酵培養基是指大生產時所用的培養基,由于發酵產物中一般含有較高比例的碳元素,因此培養基中的碳源含量也應該比種子培養基中高,如果產物的含氮量高,還應增加培養基中的氮源比例。但必須注意培養基的滲透壓,如果滲透壓太高,又會反過來抑制微生物的生長,在這種情況下可考慮用流加的方法逐步加入碳氮源。
培養基組分對發酵起著關鍵性的影響作用。工業發酵培養基與菌種篩選時所用的培養基不同,一般以經濟節約為主要原則,因此常用廉價的農副產品為原料。選擇碳源時常用山芋粉、麩支、玉米粉等代替淀粉。而用豆餅粉、黃豆粉等作為氮源。此外,還應考慮所選原料不至于影響下游的分離提取工作。由于這些天然原料的組分復雜,不同批次的原料成分各不相同,在進行發酵前必須進行培養基的優化試驗。
發酵培養基中的原料多是大分子物質,微生物一般不能直接吸收,必須通過胞外酶的作用后才能被利用,所以是一些“遲效性”營養物質。而微生物分泌的胞外酶有不少是誘導酶,為了使發酵起始階段微生物能快速繁殖,可適當在培養基中添加一些速效營養物。
微生物發酵培養基配制注意事項
注意營養物質的濃度比和C/N比
如:糖分含量要適合微生物生長才能良好,糖分過多則抑制微生物生長。一般微生物適宜C/N是25:1(元素C/N的比值,也指培養基中還原糖的含量與粗蛋白質含量的比值)。
營養物質濃度及配比合適
培養基中營養物質濃度合適時微生物才能生長良好,營養物質濃度過低時不能滿足微生物正常生長所需,濃度過高時則可能對微生物生長起抑制作用,例如高濃度糖類物質、無機鹽、重金屬離子等不僅不能維持和促進微生物的生長,反而起到抑菌或殺菌作用。
另外,培養基中各營養物質之間的濃度配比也直接影響微生物的生長繁殖和(或)代謝產物的形成和積累,其中碳氮比(C/N)的影響較大。嚴格地講,碳氮比指培養基中碳元素與氮元素的物質的量比值,有時也指培養基中還原糖與粗蛋白之比。例如,在利用微生物發酵生產谷氨酸的過程中,培養基碳氮比為4/l時,菌體大量繁殖,谷氨酸積累少;當培養基碳氮比為3/l時,菌體繁殖受到抑制,谷氨酸產量則大量增加。再如,在抗生素發酵生產過程中,可以通過控制培養基中速效氮(或碳)源與遲效氮(或碳)源之間的比例來控制菌體生長與抗生素的合成協調。
控制pH條件
培養基的pH必須控制在一定的范圍內,以滿足不同類型微生物的生長繁殖或產生代謝產物。各類微生物生長繁殖或產生代謝產物的最適pH條件各不相同,一般來講,細菌與放線菌適于在pH7~7.5范圍內生長,酵母菌和霉菌通常在pH4.5~6范圍內生長。值得注意的是,在微生物生長繁殖和代謝過程中,由于營養物質被分解利用和代謝產物的形成與積累,會導致培養基pH發生變化,若不對培養基pH條件進行控制,往往導致微生物生長速度下降或(和)代謝產物產量下降。因此,為了維持培養基pH的相對恒定,通常在培養基中加入pH緩沖劑,常用的緩沖劑是一氫和二氫磷酸鹽(如KH2PO4和K2HPO4)組成的混合物。K2HPO4溶液呈堿性,KH2PO4溶液呈酸性,兩種物質的等量混合溶液的pH為6.8。當培養基中酸性物質積累導致H+濃度增加時,H+與弱堿性鹽結合形成弱酸性化合物,培養基pH不會過度降低;如果培養基中OH-濃度增加,OH-則與弱酸性鹽結合形成弱堿性化合物,培養基pH也不會過度升高。
但KH2PO4和K2HPO44緩沖系統只能在一定的pH范圍(pH6.4~7.2)內起調節作用。有些微生物,如乳酸菌能大量產酸,上述緩沖系統就難以起到緩沖作用,此時可在培養基中添加難溶的碳酸鹽(如CaCO3)來進行調節,CaCO3難溶于水,不會使培養基pH過度升高,但它可以不斷中和微生物產生的酸,同時釋放出CO2,將培養基pH控制在一定范圍內。
在培養基中還存在一些天然的緩沖系統,如氨基酸、肽、蛋白質都屬于兩性電解質,也可起到緩沖劑的作用。
原料來源的選擇
在配制培養基時應盡量利用廉價且易于獲得的原料作為培養基成分,特別是在發酵工業中,培養基用量很大,利用低成本的原料更體現出其經濟價值。例如,在微生物單細胞蛋白的工業生產過程中,常常利用糖蜜(制糖工業中含有蔗糖的廢液)、乳清(乳制品工業中含有乳糖的廢液)、豆制品工業廢液及黑廢液(造紙工業中含有戊糖和己糖的亞硫酸紙漿)等都可作為培養基的原料。再如,工業上的甲烷發酵主要利用廢水、廢渣作原料,而在我國農村,已推廣利用人畜糞便及禾草為原料發酵生產甲烷作為燃料。另外,大量的農副產品或制品,如鼓皮、米糠、玉米漿、酵母浸膏、酒糟、豆餅、花生餅、蛋白胨等都是常用的發酵工業原料。
滅菌處理
要獲得微生物純培養,必須避免雜菌污染,因此對所用器材及工作場所進行消毒與滅菌。對培養基而言,更是要進行嚴格的滅菌。對培養基一般采取高壓蒸汽滅菌,一般培養基用1.05kg/cm2,121.3℃條件下維持15~30min可達到滅菌目的。在高壓蒸汽滅菌過程中,長時間高溫會使某些不耐熱物質遭到破壞,如使糖類物質形成氨基糖、焦糖,因此含糖培養基常在0.56kg/cm2,112.6℃15~30min進行滅菌,某些對糖類要求較高的培養基,可先將糖進行過濾除菌或間歇滅菌,再與其他已滅菌的成分混合;長時間高溫還會引起磷酸鹽、碳酸鹽與某些陽離子(特別是鈣、鎂、鐵離子)結合形成難溶性復合物而產生沉淀,因此,在配制用于觀察和定量測定微生物生長狀況的合成培養基時,常需在培養基中加入少量螯合劑,避免培養基中產生沉淀,常用的螯合劑為乙二胺四乙酸(EDTA)。還可以將含鈣、鎂、鐵等離子的成分與磷酸鹽、碳酸鹽分別進行滅菌,然后再混合,避免形成沉淀;高壓蒸汽滅菌后,培養基pH會發生改變(一般使pH降低0.2),可根據所培養微生物的要求,在培養基滅菌前后加以調整。
相同點:營養豐富完全,PH相對穩定,都有利于菌體生長繁殖。
不同點:種子培養基的碳源、氮源都是速效或利于利用的,磷酸鹽濃度稍高些。發酵培養基碳源、氮源速效與遲效相互搭配,以遲效為主。
相關新聞推薦
1、不同包裝方式下清蒸大黃魚貯藏過程中PH值、菌落總數、菌群等的變化情況(一)
